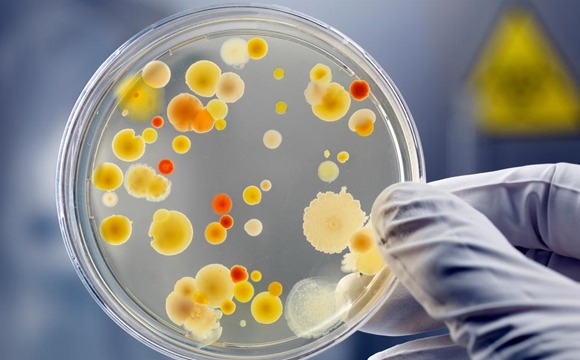
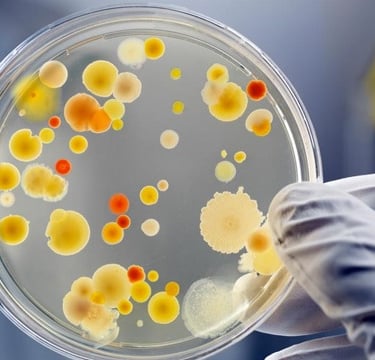

The Central Drugs Standard Control Organization (CDSCO) Registered: CRO/MH/2025/000137
From Sample to Submissions, Powering Clinical Trials with Precision Diagnostics


Partner with RamAayanaM Laboratories for Reliable Global Diagnostics and Research Lab Services
RamAayanaM Laboratories
Who we are
RamAayanaM Laboratories Private Limited is a cutting-edge global diagnostic and research laboratory, with a clear mission: to deliver precise, reliable, and timely laboratory services that empower better healthcare decisions and advance clinical research worldwide.
We specialize in a comprehensive range of routine diagnostic tests—including biochemistry, clinical pathology, haematology, culture & sensitivity, serology, and special tests—catering to patients, physicians, and healthcare providers with utmost accuracy and care.
At the same time, we serve as a trusted partner for clinical trials, providing specialized laboratory support that complies with global standards such as GLP and GCP. Our expertise spans sample processing, bioanalytical support, and regulatory-compliant data management, making us a preferred central lab for sponsors and CROs conducting studies in India and beyond.
Key Highlights
Highly skilled scientists, technologists, and clinical experts with deep experience in diagnostic testing and clinical research.
We offer a comprehensive range of routine diagnostic tests designed to support general health, disease prevention, and clinical management,
Comprehensive Testing Portfolio: Biochemistry, Clinical Pathology, Haematology, Culture & Sensitivity, Serology, and Specialized Tests
ISO 9001:2015 Certified Lab
GLP and GCP Compliant processes ensuring high-quality, audit-ready results
Advanced Bioanalytical instrumentation: LC-MS, HPLC, GC-MS for accurate, reproducible results.
Fully equipped with automated Analyzers, ELISA Systems, culture and sensitivity instruments
GLP-compliant facilities with temperature-controlled sample processing areas.
Services

Biochemistry Lab tests
We conduct comprehensive biochemistry testing to evaluate organ function, metabolism, and disease markers.
Blood Sugar Fasting (BSF) and Postprandial (PP) Test (Biochemistry)
Blood Sedimentation Rate (BSR), Blood urea
Blood urea nitrogen (BUN), Serum Creatinine Test
Creatine Phosphokinase (CPK), Creatine Kinase-MB (CK-MB)
SGOT (Serum Glutamate Oxaloacetate Transaminase)
SOP for SGPT (Serum Glutamate Pyruvate Transaminase)
Serum Bilirubin, Alkaline Phosphatase (ALP), Serum Cholesterol, Serum Triglycerides, Serum Amylase, Serum Lipase, Serum Uric Acid, Serum Electrolyte Calcium, Serum Proteins Test.
Clinical Pathology
Our clinical pathology services include routine urine, stool, and body fluid analysis with expert interpretation.
We support patient diagnosis with accurate microscopic and chemical evaluations using modern equipment. We Perform following tests.
Acid-Fast Bacilli (AFB) Examination
Semen Analysis Examination
Stool Examination
Urine Pregnancy Tests (UPT)
Urine routine test
Culture
We perform microbiological culture tests to detect bacterial, fungal, and other microbial infections.
Sterile techniques and controlled environments ensure reliable identification and sensitivity profiling. We perform following test.
Urine Culture
Pus culture
Stool Culture
Sputum Culture
Blood Culture
Haematology lab test
Our hematology lab offers complete blood counts (CBC), coagulation profiles, and peripheral smear analysis.
Automated analyzers and manual validation by experts ensure diagnostic precision in blood-related disorders. We perform following test.
Complete Blood Count (CBC) Test
Erythrocyte Sedimentation Rate (ESR) Test
Malaria Parasite (MP) and Malaria Parasite Antigen (MP Antigen) Testing
Bleeding Time (BT) and Clotting Time (CT) Testing
Blood Group Test
Prothrombin Time (PT) and International Normalized Ratio (INR) Testing
Glucose-6-Phosphate Dehydrogenase (G6-PD) Test
Hemoglobin A1c (HbA1c) test
Mantoux Test
Profiles (Liver, Kidney, Thyroid, Cardiac, etc.)
We offer a wide range of diagnostic profiles to assess organ health and detect early abnormalities.
Our bundled tests provide a holistic view of patient well-being for targeted and preventive care.
Lipid profile test
Renal Profile test
Liver profile test
Antenatal Care (ANC) Profile test
Serology Test
We provide serological testing for detecting antibodies and antigens related to infections and immunity.
Our ELISA and rapid test platforms ensure high sensitivity and specificity in immune response detection. We perform following tests
Venereal Disease Research Laboratory (VDRL) test
HIV serological tests
Hepatitis B Surface Antigen (HBsAg) tests
Antistreptolysin O (ASO) titer
C-Reactive Protein (CRP) test
Rheumatoid Arthritis (RA) test
HCV serological test
Widal test
Our specialized tests include hormonal assays, tumor markers, vitamin levels, and allergy panels.
We use cutting-edge diagnostic platforms like chemiluminescence and immunoassays for accurate insights. At Our Laboratory we perform following tests but not limited to only
Leptospira Test
Dengue NS 1 Test
Dengue IgM & IgG Antibody Test
Chikungunya IgM & IgG antibody tests
Special Tests


Our laboratory is equipped with advanced diagnostic technologies and automation systems to ensure precision, speed, and reliability. We offer a comprehensive range of patient diagnostics and clinical research services, adhering to the highest standards of quality and compliance.
Predict the future by understanding today with RamAayanaM Laboratories
Empowering better health outcomes through scientific excellence, innovation, and global collaboration.
Subscribe to our newsletter
Quick Links
Socials
Copyright © 2025. RCS - RamAayanaM Clinical Solution. All Rights Reserved
Registered office
Diva East, Thane, Maharashtra, India
Miami, FL, USA
Branch office
Vikhroli West, Mumbai, Maharashtra, India
Vila Franca de Xira, Portugal
Madrid, Spain
Contact us:
+91-8979335208
+91-9820507220
E-mail:
info@rclinicalsolution.com
bd@rclinicalsolution.com